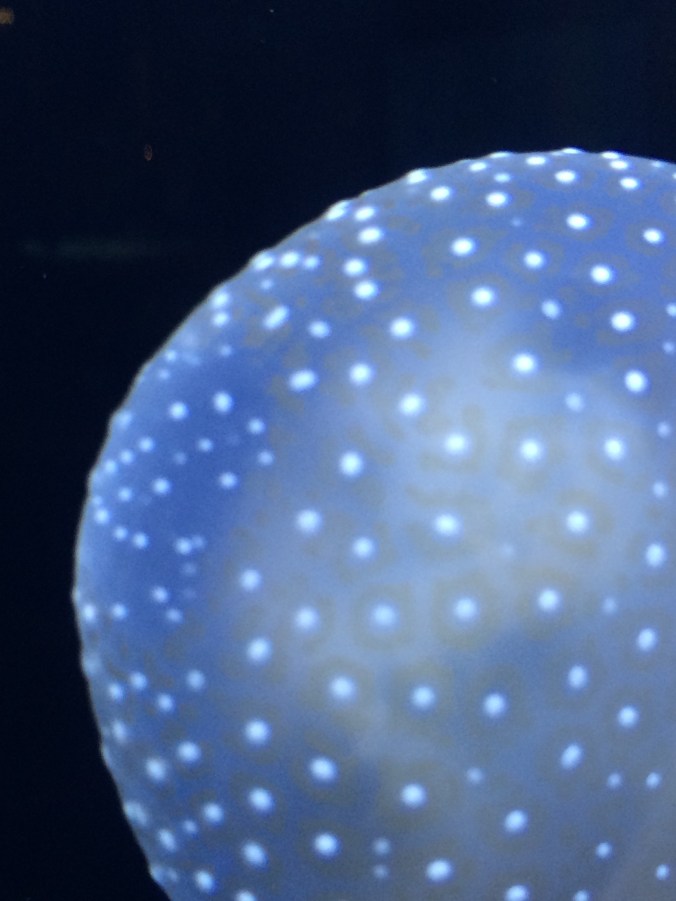

I love my little family…even though, I am totally outnumbered!!
Yes. I am the only girl amongst all the guys: my husband, 2 adventurous boys, and, now, 2 rambunctious cats! Haha! Evenso, I wouldn’t change it for the world. I love them all. ❤️
I love that my husband is very much a manly man, totally unpredictable and adventurous; yet, he can be so tender and sweet to me. He seems to be able to read my mind at just the right moments, and sometimes even seems to know how to put my feelings into words better than I do. He can be compassionate and loving with our boys, and he can get them so excited and playful, it’s hard to wind them down! He is a man of deep integrity and strong character, and I never have to wonder if he’s telling me the truth, because he is a complete truth speaker… sometimes, even to the point of almost hurting my feelings (I’m quite a sensitive creature), but it’s always for my good not harm. I am so very proud to be his wife.
I love that our boys are full of life, love and laughter. They’re always ready to play, and yet they enjoy their quiet, down times, as well. Our oldest is consumed with music. Rhythm and verse being what fuels his soul. He enjoys the social scene, always wanting to get with friends and go to where ever the action will find him. Our youngest finds his creativity in building, reading and searching out what nature has to offer him. He loves to learn new facts, especially those concerning dinosaurs, science or the Bible. He has a very curious and insatiable thirst for knowledge.
The boys are so very different; yet, they find themselves meeting up on the same road when it comes to video games, funny videos and things of the Bible. They love to laugh together, and they love to have intriguing conversations with their daddy about the end of times, creation and so many things concerning God. They are fun-loving and oh, so fun to love! Sometimes, they run circles around me, and I need an extra nap, but I wouldn’t trade either of them for all the riches in the world! I love them so much; my heart just feels it might bust.
Those two little kittens, who are quickly growing into full grown cats are actually little sweethearts, too. When I go to spend time with them, they are so loving and kind. They sound like little purr boxes, almost immediately, when I walk through the door, and even when they’re in a energetic, playful mood, they want me to pet them and love on them. They’re so sweet!
I’ve always heard that when you have all boys, the mom gets to be queen of her castle. I’m not sure if I can say that, but I can definitely say, I love my little family, and most days (cuz we all have those days when we don’t feel quite queen-ish! 😜 haha!), I feel loved and cherished by them. I am truly a blessed woman, and my heart stays full to overflowing with my love for them. I am so thankful God saw fit to bless me so abundantly!!
Ps. For those of you reading this, and you know our family, I know these pics are many moons past, but I couldn’t resist sharing them. (Plus, you know, I don’t give out current pics of my not-so-little fellas!)
…Sweet, sweet memories of precious days gone past…way too fast!! ❤️